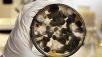

Shopping

Questo Motorola è il pieghevole da prendere oggi

Il siero viso con l'ingrediente che non ti aspetti. Ora in sconto
DiLei

The Voice, l'ultima volta di Antonella Clerici: cosa succede

Sandro Giacobbe, chi è la moglie più giovane di 27 anni
Magazine

Un Professore 3, tra gaffe in scena e proteste social: cosa è successo

Garlasco, il giallo delle luci le parole dell’ex perito sul Dna di Sempio
DiLei Girlz

Preppy Chic: la polo di Taylor Swift è l'ossessione del momento

Emis Killa mostra le sue fragilità: l'album che sorprende

L'amore ai tempi dei social: perché nascondiamo il fidanzato

Tecnopolimeri: cosa sono e perché sono una diventati una necessità
QF Green

Cura, equità, prevenzione: la salute è di tutte

Guarnizioni e sostenibilità: strategie per un futuro sostenibile

Riciclare in 50 anni è servito? La risposta dell'Ue

Tecnologie assistive: dal bastone intelligente all'APP
QuiFinanza

L'Ue ha un problema: Putin "minaccia" 8 Paesi europei

Missili e droni sull'Italia, Crosetto annuncia lo scudo
Offerte della settimana

Pc
Ricondizionato, 256gb e schermo da 14" Lenovo
-%
317€
Scopri

Tritatutto
Compatto, potente, con lama in acciaio inox KitchenAid
-32%
Scopri

Cuscino in gel
Sollievo e comfort per chi resta seduto a lungo InnovaGoods
-25%
Scopri
DiLei Home&Living

Spettacolare tenuta di 36mila mq: in vendita a 4 milioni